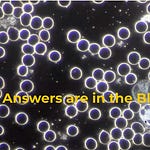

After much contemplation, and admittedly some persuasion, I’ve finally decided to launch a podcast.
The final straw that helped me make the decision came about from a meeting I had at Confluence - the result of which forms the second episode of this podcast - so stay tuned!
I’ve been aware for some time that many people like to listen while they drive/travel/work/play and often don’t have much time to read. So I’ve decided that, as well as conversations with amazing people, I’ll also record what I regard as the more important of my Substack articles and release them as podcasts.
Thank you for joining me in this new adventure.
Dawn 🌹
Podcast music: Intro and Outro - Eros Love by Harris Heller.